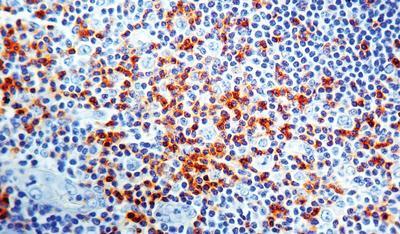

Cd45ro T Cell Conc. Mab 1ml ,Each
$ 584.20
|
|
Details:
T Cell, CD45RO^ Clone number UCHL-1, This antibody reacts with a 180 kD glycoprotein of CD45 family, occurring on most thymocytes and activated T cells but only on the portion of the resting T cells. It reacts with most thymocytes, a subpopulation of resting cells within both the CD4 and CD8 subsets and mature activated T cells.
Additional Information
| SKU | 2320987 |
|---|---|
| UOM | EACH |
| UNSPSC | 12352203 |
| Manufacturer Part Number | MOB 043 |
| Product Dimensions | 8X5X4 Inches |
| Product Weight | 1 |

